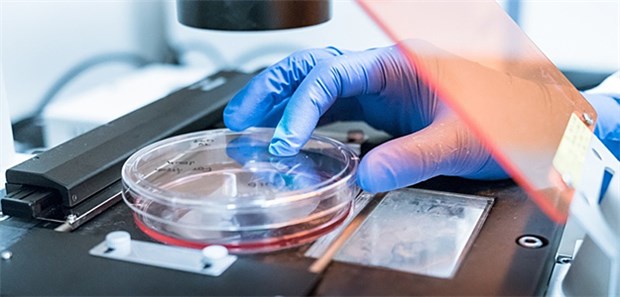

Forschung und Lehre
Allgemeinmediziner sehen sich auch als Spitzenforscher
DEGAM-Präsidentin Baum sieht gute Chancen, Forschung und Lehre mit der Arbeit in der Praxis zu verbinden.
Veröffentlicht:
Zellkulturen unterm Mikroskop: Auch Hausärzte sind in der Forschung aktiv, so der Tenor auf dem DEGAM-Kongress. © sinitar / stock.adobe.com
© sinitar / stock.adobe.com
DÜSSELDORF. Hausärzte müssen sich mit ihren Forschungsaktivitäten nicht hinter anderen Fachgruppen verstecken. "Die Allgemeinmedizin liefert genauso Spitzenforschung ab wie andere Disziplinen", sagte Professor Stefan Wilm anlässlich des 51. Kongresses für Allgemeinmedizin und Familienmedizin, der am Donnerstag in Düsseldorf begonnen hat.
Der Wissenstransfer von der Forschung in den hausärztlichen Alltag ist eines der zentralen Anliegen des Kongresses. Die Bedeutung der allgemeinmedizinischen Forschung für die Arbeit in den Praxen zeige das Risikoprognose-Programm für Herzinfarkt und Schlaganfall "Arriba", sagte Kongresspräsident Wilm, der Leiter des Instituts für Allgemeinmedizin an der Uniklinik Düsseldorf ist. Es habe die Patientenversorgung durch eine klare Strukturierung verbessert. Große Bedeutung hätten auch die wissenschaftlichen Leitlinien der Deutschen Gesellschaft für Allgemeinmedizin und Familienmedizin (DEGAM).
Zwar sei der Forschungsbeitrag der Allgemeinmedizin noch nicht in allen Köpfen angekommen, gerade durch die Institutionalisierung der Allgemeinmedizin an den medizinischen Fakultäten habe sich aber vieles verbessert. "Allerdings gibt es eine Universität, die einen Lehrstuhl für Allgemeinmedizin besetzen will und keinen Allgemeinmediziner in der Berufungskommission hat." Um welche Universität es sich dabei handelt, wollte Wilm allerdings nicht sagen.
Forschung und Lehre lassen sich gut mit der Arbeit in der hausärztlichen Praxis vereinbaren, sagte DEGAM-Präsidentin Professor Erika Baum. Sie selbst praktiziert dieses Modell bereits seit 35 Jahren. "Ich erlebe die Praxis immer wieder als den Ort, an dem ich Kraft schöpfe und Anregungen für die Forschung erhalte."
Das Interesse an der Forschung ist einer der Gründe dafür, dass junge Mediziner nicht mehr rund um die Uhr für die Patientenversorgung in den Praxen zur Verfügung stehen wollen, sagte Dr. Christian Rechtenwald, Sprecher für Internationales der Jungen Allgemeinmedizin Deutschlands. Er selbst ist seit diesem Jahr Facharzt und in einer Praxis auf dem Land niedergelassen. "Ich möchte einen gewissen Freiraum für die Forschung haben", betonte Rechtenwald. Mit diesem Wunsch stehe er nicht allein da. "Die jungen Leute wollen teilnehmen und ihr Fach gestalten."